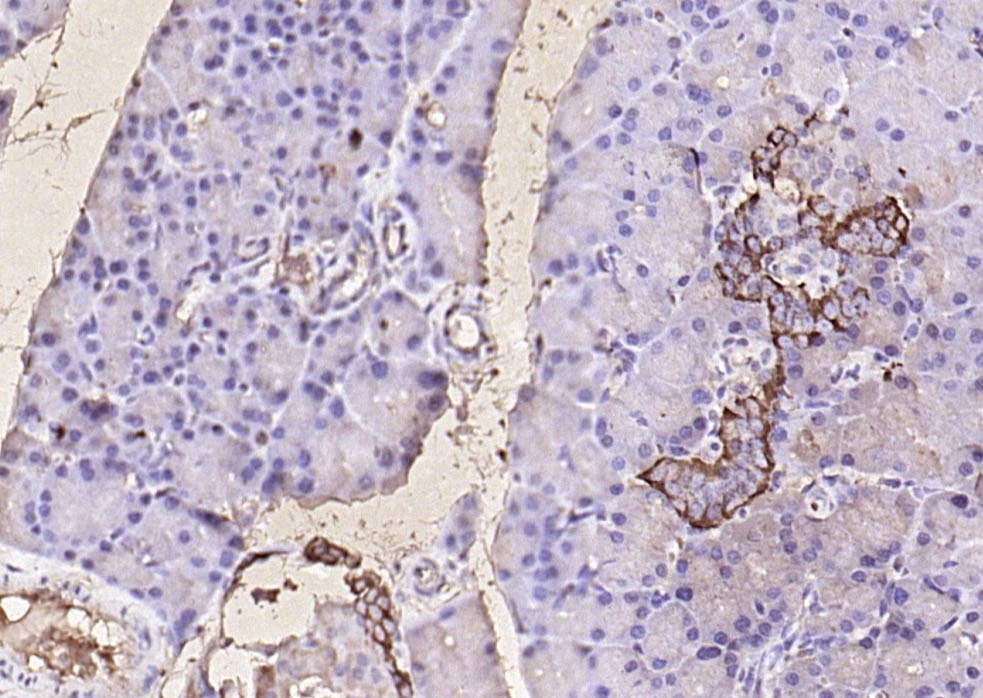

购物车
 您的购物车当前为空
您的购物车当前为空
Anti-GCG Polyclonal Antibody 是一种 Rabbit 抗体,靶向 GCG。Anti-GCG Polyclonal Antibody 可用于 IF,IHC-Fr,IHC-P。
别名 Oxyntomodulin, OXY, OXM, Incretin Hormone, GRPP, Glucagon-Like Peptide 2, Glucagon-Like Peptide 1, Glucagon, GLP-2, GLP-1, Glicentin-Related Polypeptide, Glicentin, GCG
Anti-GCG Polyclonal Antibody 是一种 Rabbit 抗体,靶向 GCG。Anti-GCG Polyclonal Antibody 可用于 IF,IHC-Fr,IHC-P。
| 规格 | 价格 | 库存 | 数量 |
|---|---|---|---|
| 50 μL | ¥ 1,160 | 5日内发货 | |
| 100 μL | ¥ 1,975 | 5日内发货 | |
| 200 μL | ¥ 2,795 | 5日内发货 |
TargetMol的所有产品仅用作科学研究或药证申报,不能被用于人体,我们不向个人提供产品和服务。请您遵守承诺用途,不得违反法律法规规定用于任何其他用途。
| 产品描述 | Anti-GCG Polyclonal Antibody is a Rabbit antibody targeting GCG. Anti-GCG Polyclonal Antibody can be used in IF,IHC-Fr,IHC-P. |
| 别名 | Oxyntomodulin, OXY, OXM, Incretin Hormone, GRPP, Glucagon-Like Peptide 2, Glucagon-Like Peptide 1, Glucagon, GLP-2, GLP-1, Glicentin-Related Polypeptide, Glicentin, GCG |
| Ig Type | IgG |
| 反应种属 | Human,Mouse,Rat |
| 验证活性 | 1. Paraformaldehyde-fixed, paraffin embedded (mouse pancreas); Antigen retrieval by boiling in sodium citrate buffer (pH6.0) for 15 min; Block endogenous peroxidase by 3% hydrogen peroxide for 20 min; Blocking buffer (normal goat serum) at 37°C for 30 min; Antibody incubation with (GLP-1) Polyclonal Antibody, Unconjugated (TMAB-00750) at 1:200 overnight at 4°C, followed by operating according to SP Kit (Rabbit) instructionsand DAB staining. 2. Paraformaldehyde-fixed, paraffin embedded (rat pancreas); Antigen retrieval by boiling in sodium citrate buffer (pH6.0) for 15 min; Block endogenous peroxidase by 3% hydrogen peroxide for 20 min; Blocking buffer (normal goat serum) at 37°C for 30 min; Antibody incubation with (GLP-1) Polyclonal Antibody, Unconjugated (TMAB-00750) at 1:200 overnight at 4°C, followed by operating according to SP Kit (Rabbit) instructionsand DAB staining. 3. Paraformaldehyde-fixed, paraffin embedded (human pancreatic cancer); Antigen retrieval by boiling in sodium citrate buffer (pH6.0) for 15 min; Block endogenous peroxidase by 3% hydrogen peroxide for 20 min; Blocking buffer (normal goat serum) at 37°C for 30 min; Antibody incubation with (GLP-1) Polyclonal Antibody, Unconjugated (TMAB-00750) at 1:200 overnight at 4°C, followed by operating according to SP Kit (Rabbit) instructionsand DAB staining. |
| 应用 | IFIHC-FrIHC-P |
| 推荐剂量 | IHC-P: 1:100-500; IHC-Fr: 1:100-500; IF: 1:100-500 |
| 抗体种类 | Polyclonal |
| 宿主来源 | Rabbit |
| 亚细胞定位 | Secreted. |
| 组织特异性 | Glucagon is secreted in the A cells of the islets of Langerhans. GLP-1, GLP-2, oxyntomodulin and glicentin are secreted from enteroendocrine cells throughout the gastrointestinal tract. GLP1 and GLP2 are also secreted in selected neurons in the brain. |
| 构建方式 | Polyclonal Antibody |
| 纯化方式 | Protein A purified |
| 性状 | Liquid |
| 缓冲液 | 0.01M TBS (pH7.4) with 1% BSA, 0.02% Proclin300 and 50% Glycerol. |
| 浓度 | 1 mg/mL |
| 研究背景 | Glucagon plays a key role in glucose metabolism and homeostasis. Regulates blood glucose by increasing gluconeogenesis and decreasing glycolysis. A counterregulatory hormone of insulin, raises plasma glucose levels in response to insulin-induced hypoglycemia. Plays an important role in initiating and maintaining hyperglycemic conditions in diabetes. |
| 免疫原 | KLH conjugated synthetic peptide: human GLP-1 |
| 抗原种属 | Human |
| 基因名称 | GCG |
| 基因ID | |
| 蛋白名称 | Pro-glucagon |
| Uniprot ID | |
| 研究领域 | Integration of energy metabolism,Hormones,Endoderm,Integration of energy,Cancer,Hormones,Endoderm |
| 功能 | Glucagon plays a key role in glucose metabolism and homeostasis. Regulates blood glucose by increasing gluconeogenesis and decreasing glycolysis. A counterregulatory hormone of insulin, raises plasma glucose levels in response to insulin-induced hypoglycemia. Plays an important role in initiating and maintaining hyperglycemic conditions in diabetes. GLP-1 is a potent stimulator of glucose-dependent insulin release. Play important roles on gastric motility and the suppression of plasma glucagon levels. May be involved in the suppression of satiety and stimulation of glucose disposal in peripheral tissues, independent of the actions of insulin. Have growth-promoting activities on intestinal epithelium. May also regulate the hypothalamic pituitary axis (HPA) via effects on LH, TSH, CRH, oxytocin, and vasopressin secretion. Increases islet mass through stimulation of islet neogenesis and pancreatic beta cell proliferation. Inhibits beta cell apoptosis. GLP-2 stimulates intestinal growth and up-regulates villus height in the small intestine, concomitant with increased crypt cell proliferation and decreased enterocyte apoptosis. The gastrointestinal tract, from the stomach to the colon is the principal target for GLP-2 action. Plays a key role in nutrient homeostasis, enhancing nutrient assimilation through enhanced gastrointestinal function, as well as increasing nutrient disposal. Stimulates intestinal glucose transport and decreases mucosal permeability. Oxyntomodulin significantly reduces food intake. Inhibits gastric emptying in humans. Suppression of gastric emptying may lead to increased gastric distension, which may contribute to satiety by causing a sensation of fullness. Glicentin may modulate gastric acid secretion and the gastro-pyloro-duodenal activity. May play an important role in intestinal mucosal growth in the early period of life |
| 分子量 | Theoretical: 21 kDa. |
| 储存方式 | Store at -20°C or -80°C for 12 months. Avoid repeated freeze-thaw cycles. |
| 运输方式 | Shipping with blue ice. |